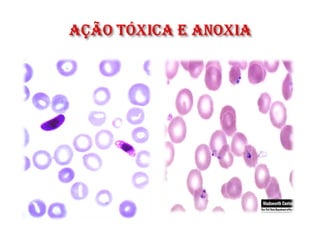

O documento aborda os conceitos fundamentais da parasitologia, focando nas relações entre parasitas, hospedeiros e o meio ambiente. São discutidos diferentes tipos de interações, como comensalismo, mutualismo, simbiose e competições, além de definir termos essenciais como hospedeiro definitivo e intermediário, vetor e ciclos biológicos. Também são apresentados conceitos sobre a classificação, nomenclatura e tipos de doenças parasitárias, bem como suas dinâmicas de distribuição na população.